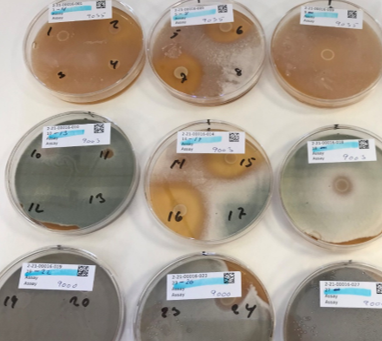

Skimmelvækst er årsag til meget madspild
Skimmelvækst er hovedårsag til, at en tredjedel af alle fødevarer kasseres. Vækst af skimmel ødelægger kvaliteten, bidrager til grim lugt og smag, og kan være sundhedsskadelig. Vi har undersøgt, om mælkesyrebakterier kan hindre vækst og/eller produktion af ochratoxin A i fermenterede spegepølser.
På verdensplan bliver mere end en tredjedel af alle fødevarer kasseret, og over halvdelen af dette madspild sker i supermarkeder og hos forbrugerne, hvor uønsket vækst af skimmel er hovedårsagen.
Vækst af skimmel ødelægger kvaliteten af fødevarer, fordi det ser uappetitligt ud, det lugter og smager grimt - og fødevarerne bliver ofte bløde.
En anden årsag til at have fokus på skimmelvækst er, at nogle skimmel kan producere mykotoksiner, som kan have en sundhedsskadelig effekt på dyr og mennesker. Nogle af de mykotoksiner, der er mest opmærksomhed på i fødevarer, er aflatoksin og ochratoksin A. Men også forekomst af andre mykotoksiner er reguleret via EU kommissionens forordning nr. 1881/2006 af 19. december 2006 om fastsættelse af grænseværdier for bestemte forurenende stoffer i fødevarer.
I 2020 udgav Den Europæiske Fødevaresikkerhedsautoritet, EFSA, en udvidet risikoanalyse for forekomst af ochratoksin A (OTA) i fødevarer1). Rapporten konkluderede, at de vigtigste kilder til indtag af OTA er konserveret kød, ost, korn og kornbaserede fødevarer.
I et nyligt afsluttet projekt, støttet af Svineafgiftsfonden, har DMRI, Teknologisk Institut undersøgt, om mælkesyrebakterier kan hindre vækst og/eller produktion af OTA i fermenterede spegepølser.
Mælkesyrebakterier kan hæmme mange mikroorganismer
Ved fermentering af fødevarer fx kød, mælk og planter anvendes ofte mælkesyrebakterier, fordi de sænker pH og dermed bidrager væsentligt til produkternes smag og konservering.
Mælkesyrebakterier kan også producere forskellige metabolitter, som kan hindre vækst af uønskede mikroorganismer. Denne effekt er beskrevet i et utal af videnskabelige artikler, og samlet kaldes det biokonservering eller biobeskyttelse. Biokonservering har vist sig at virke i mange forskellige fødevarer.
Ved en screening af mælkesyrebakteriers evne til at hæmme vækst af skimmel på forskellige vækstmedier inkuberet anaerobt hhv. aerobt (se figur 1) fandt vi, at ca. en tredjedel af de testede bakteriestammer kunne hæmme væksten af skimmel. De mælkesyrebakterier, som havde effekt, var hovedsageligt Lactobacillus plantarum og Lactobacillus sakei stammer. De mælkesyrebakterier, som gav den største hæmning af skimmel, blev udtaget til forsøg i spegepølser.
Figur 1. Et eksempel på hæmning hhv. ingen hæmning af skimlernes vækst. Kolonne til venstre P. nordicum, kolonne i midten P. brevicompactum og kolonne til højre P. salamii. Spot 6, 15 og 24 er samme mælkesyrebakterie. Spot 7, 16 og 25 er en anden mælkesyrebakterie. Begge kulturer kan hæmme skimmelvækst.
Effekt af fermentat i spegepølsemodel
En mulig applikation af mælkesyrebakterier er at tilsætte et fermentat - dvs. en bouillon - hvori mælkesyrebakterien har vokset. En af de lovende stammer blev testet i en kødmodel med pH 5 og en vandaktivitet på 0,95 (8 pct. salt/vand). Resultaterne viste, at fermentatet ikke kunne hindre vækst af skimlen Penicillium nordicum, som producerer OTA. Men det var interessant, at OTA ikke kunne påvises i nogen af prøverne, selv om der var vækst af skimlen.
Måske er årsagen til, at der ikke ses toksinproduktion i dette forsøg, at produktet har et højt saltindhold, idet lav vandaktivitet er kendt for at nedsætte toksinproduktionen. I litteraturen er der også eksempler på, at produktionen af OTA på agarplader opbevaret ved 25°C falder fra 47 enheder ved 5 pct. NaCl til otte enheder ved 10 pct. salt2).
Effekt af mælkesyrebakterier i minispegepølser
En anden mulig applikation er at bruge mælkesyrebakterierne som starterkulturer i spegepølser.
I et screeningsassay med minispegepølser testede man en række lovende mælkesyrebakterier i to forskellige farser:
• 2 pct. salt, 0,8 pct. dextrose, 100 ppm nitrit.
• 3,5 pct. salt; 1,3 pct. dextrose, 100 ppm nitrit.
Pølserne blev fermenteret ved 24°C i to døgn. På dag tre blev temperaturen justeret til 18°C og derfra til 16°C, hvor pølserne blev tørret, indtil der blev opnået 20 pct. svind (ca. to uger). Svind, pH og skimmelvækst blev løbende målt.
Ved 20 pct. svind blev der målt OTA i pølseskindet og i selve spegepølsen. Den anvendte detektionsmetode for OTA havde en kvantificeringsgrænse på 1 ppb.
Figur 2. Minispegepølser anvendt til studie af kulturers antifungale effekt under fermentering og tørring.
Alle afprøvede kulturer kunne sænke pH i pølserne til mellem 4,7 og 5,0 på dag to, men ingen kulturer kunne fuldstændigt hæmme skimmelvæksten. Der blev fundet OTA i nogle få minipegepølser, men i langt de fleste prøver var der ingen eller kun en ganske lille produktion af OTA.
Det blev også observeret, at mængden af OTA var væsentligt højere i skindet end i selve spegepølsen.
Antifungal effekt i spegepølser
De fem mest lovende mælkesyrebakterier blev afslutningsvis testet i spegepølser, produceret i DMRI’s pilot plant. Halvdelen blev færdigproduceret i pilot plant og anvendt til sensorisk bedømmelse, og den anden halvdel blev podet med skimmel og tørret i laboratoriet.
Skimmelvæksten blev målt som diameter af kolonien under tørringen, og ved endt produktion blev pølserne analyseret for OTA. Analyser for OTA blev lavet på en skive spegepølse udtaget lige under skimmelkolonien samt på en skive skåret 1 cm fra skimmelkolonien. Der blev ikke fundet OTA i nogen af de analyserede prøver.
Figur 3. Pilot plant-producerede spegepølser. Tv.: Pølserne blev podet på dag 6 efter stopning (3 dages fermentering, tørring ved 16°C og let røgning dag 5). Th.: Skimmelvækst ved endt produktion. Pølserne blev anvendt til toksinanalyser.
Sensorisk bedømmelse af spegepølser produceret med antifungale kulturer
De udvalgte mælkesyrebakterier blev testet alene og sammen med en traditionel starterkultur, som ikke havde antifungal effekt, på agarplader i screeningsassayet.
De spegepølser, som havde et fødevaresikkerhedsmæssigt acceptabelt pH-fald og svind, blev bedømt sensorisk, og resultaterne viste, at tekstur, lugt og smag var acceptable i forhold til ønsket kvalitet af spegepølser. Den opnåede smag var meget ens i alle serier på nær for en kultur, som adskilte sig i lugt/smag ved at have en mere fermenteret/sød/våd trælugt, både alene og sammen med en traditionel starter (serie 3 og 7 i figur 4).
Figur 4. Smagsbedømmelse af spegepølser med korrekt pH-fald indenfor 48 timer. Serie 3 adskilte sig ved at have en sød/våd trælugt jf. det sensoriske panel. Af DMRI-eksperter blev den også karakteriseret som fermenteret/sydeuropæisk.
Challengetest i pilot plant 2004-2008
I perioden 2004-2008 gennemførte DMRI også en række forsøg, hvor spegepølser tilsat en traditionel starterkultur blev syrnet til pH 4,6, røget på dag 2 og dag 4 og tørret til 30 pct. svind.
I disse spegepølser blev der ikke fundet vækst af P. nordicum under produktionen på 2-3 uger. Ved endt produktion blev spegepølserne opbevaret 2-3 måneder i en plastpose (aerob) ved 20°C. I prøver podet med P. nordicum blev der påvist 1-4 ppb ochratoksin A i pølseskindet. I de spiselige dele af pølserne blev der ikke påvist OTA (<1 ppb).
Ved forsøgene blev det også vist, at vækst af skimmel på overfladerne af spegepølser kan hindres ved at anvende tarme udblødt i vand tilsat 5 pct. K-sorbat samt ved brug af røgning og tørre overflader.
Endvidere blev det vist, at hvis der er begyndende vækst af skimmel på overfladen, dvs. et svagt hvidt skær, så er vask af overfladerne med 4 pct. saltvand eller 5-10 pct. K-sorbat efterfulgt af god tørring og røgning af overfladen gode tiltag, som sikrer, at produkterne ikke får vækst af skimmel under den efterfølgende proces.
Fermentering og tørring er et godt redskab mod produktion af OTA
Resultaterne fra de gennemførte forsøg viser, at der trods vækst af P. nordicum på overfladen af spegepølser ikke kan påvises OTA i den spiselige del af produktet.
Det vurderes derfor, at det ikke er nødvendigt at kassere typiske danske spegepølser med skimmelvækst; det vil være tilstrækkeligt blot at bortskære den del af produktet, hvor skimlen vokser. Da der i nogle forsøg er fundet lidt ochratoksin i overfladen, anbefales det at fjerne produkt i en afstand på 1 cm fra skimlen.
Fund af OTA i udenlandske fermenterede pølser
Det skal dog bemærkes, at internationale screeninger for forekomst af OTA i kød og kødprodukter viser, at der ved fund af OTA kan måles koncentrationer på 0,2-5 ppb og helt op til 691 ppb3). I reviewet er der dog ingen beskrivelse af fremstillingsprocedure, produktets opbevaring, pH eller vandaktivitet3). Noget tyder på, at pH-faldet i pølserne ikke er så hurtigt som i dansk producerede spegepølser, men dette er ikke verificeret.
Et af de spegepølseprodukter, der er målt OTA i, er den spanske pølse ”salchichón”. Dette produkt er kendetegnet ved langsomt pH-fald under saltning/modning/tørring ved 12°C i 26 dage. Toksinproduktionen kunne måles efter 14 dage, hvor pH fortsat var 5. Først i slutningen af produktionen, som er på 26 dage, blev der målt pH på 4,74).
Et andet studium viste i et modelmedium bestående af salchichónpølse og agar, at P. nordicum ikke producerede OTA ved aw 0,87 og lagring ved 10°C. Ved aw 0,84 var der ingen OTA-produktion ved op til 30°C. I studiet blev vækst og OTA-produktion af P. verrucosum også undersøgt. Her viste resultaterne, at kun ved aw over 0,902 og temperaturer over 10°C kunne der måles OTA5).
Andre har testet, hvordan forskellige kombinationer af gær, starterkultur og skimmel kunne hindre produktion af OTA i et salchichón-baseret agar medium (pH 5,3-5,5; aw 0,95 hhv. 0,98) opbevaret ved 15°C og 20°C i 14 dage. Studiet viste, at skimlerne kunne vokse på agaren, men der kunne ikke måles OTA i substratet. Det er uvist hvorfor. Desværre er der ingen pH-målinger af mediet under de 14 dages inkubation. Den kommercielle starterkultur var Texel®ELCE Br (Danisco) bestående af Pediococcus pentosaceus, Lactobacillus sakei, Staphylococcus carnosus, Staphylococcus xylosus og Debaryomyces hansenii6).
Et studie med laboratoriemedier viste, at produktionen af OTA fra P. nordicum blev markant reduceret ved 15°C versus 25°C, og at der ved pH 4 var væsentlig mindre OTA-produktion end ved pH 5 og derover. Ligeledes blev det vist, at saltkoncentrationen ikke har nogen væsentlig betydning7).
Det har således ikke været muligt fuldstændigt at verificere hypotesen om, at så længe pH er under 5 i en fermenteret spegepølse, så er der ikke risiko for produktion af OTA. Det er uvist, hvor grænserne for pH og temperaturer præcist ligger. For at styrke en beslutning om, at spegepølser med skimmelvækst er sikre at spise, dersom stykket med skimmel blot skæres fra 1 cm over skimmelkolonien (som for faste oste), vil det være interessant at få belyst, om det også gælder, hvis der har været vækst af andre ochratoksinproducerende skimmelstammer end dem, der er testet i de gennemførte forsøg.
Hvis der kan sættes guidelines for, hvordan produktionen fx temperatur, pH-fald, tørringsforhold og vandaktivitet kan reducere skimmelvæksten så meget, at der ikke dannes mere toksin, end at fraskær af den del af produkter med synlig skimmel er tilstrækkelig i forhold til fødevaresikkerhed, vil madspild og tilbagekald kunne reduceres (som for hårde oste, hvor anbefalingen blot er, at man fraskærer stykket med skimmelvækst på hårde oste, FVST, 20228))
Figur 5. Illustration af fraskær 1 cm fra kolonien.
Referencer:
- Risk assessment of ochratoxin A in food - 2020 - EFSA Journal - Wiley Online Library.
- Silva Sonjak, Mia Licen, Jens Christian Frisvad, Nina Gunde-Cimerman (2011). Salting of dry-cured meat. A potential cause of contamination with the ochratoxin A-producing species Penicillium nordicum. Food Microbiology Volume 28, Issue 6, September 2011, Pages 1111-1116.
- Tolosa, J., Ruiz, MJ., Ferrer, E., Vila-Donat, P. (Rev. Toxicol (2020) 37: 106-110).
- Delgado, J.; Rondán, J.J., Nunez, F. & A. Rodriguez (2021) Influence of an industrial dry-fermented sausage processing on ochratoxin A production by Penicillium nordicum. Int. J. of Food Microbiology 339 (2021) 109016.
- Rodriguez, A., Capela, D., Medina, A., Cordoba, J.J. & N. Magan (2015). Relationship between ecophysiological factors, growth and ochratoxin A contamination of dry-cured sausage base matrices. Int. J. of Food Microbiology 194 (2015) 71-77.
- Mefta, S., Abid, S, Días, T and P. Rodrigues (2018) Effect of dry-sausage starter culture and endogenous yeasts on Aspergillus westerdijkiae and Penicillium nordicum growth and OTA production. LWT - Food Science and Technology, 87, 250-258.
- Geisen, R. (2004) Molecular screening of environmental conditions influencing the induction of Ochratoxin A biosynthesis genes in penicillium nordicum. Mol. Nutr. Food. Res. 48, 530-540.
- FVST (2022). Mug på mad: brød, ost, frugt og grønt mm. (skær mug af hård ost) https://www.foedevarestyrelsen.dk/Foedevarer/kend_kemien/Sider/Specifikke-foedevarer.aspx#.
Artiklen er publiceret i Plus Proces, nr. 5, 2022.